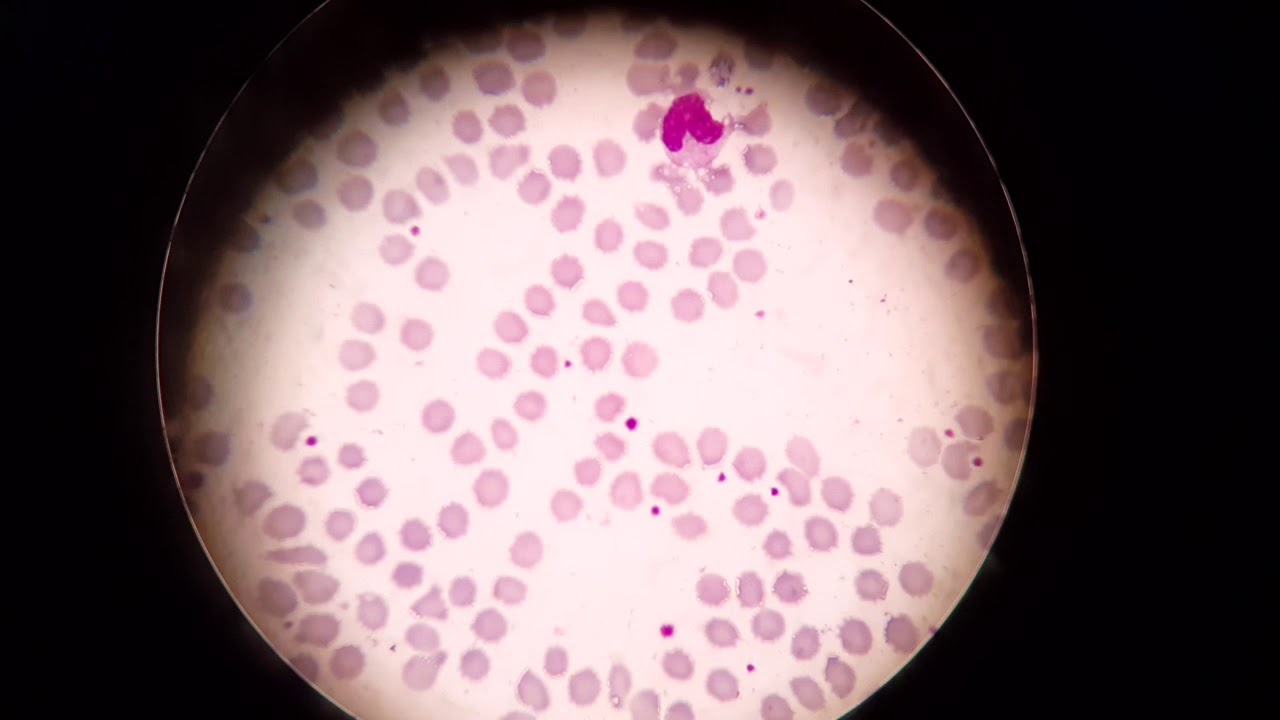
Putar video Trombosit dan Eritrosit sekarang Trombosit dan Eritrosit

WebSedikit berbeda dengan sel darah putih dan merah, trombosit sebenarnya bukan sel. Trombosit atau kadang disebut juga keping darah adalah sebuah fragmen. Web8. Gambar Mikroskop SEM (Scanning Electron Microscope) Sesuai dengan namanya, mikroskop SEM adalah salah satu varian mikroskop elektron yang memiliki.
Gambar Trombosit Di Mikroskop, Trombosit dan Eritrosit, 6.39 MB, 04:39, 3,022, ATLM Indonesia, 2021-03-08T21:49:21.000000Z, 3, Makanan Yang Bisa Meningkatkan Fungsi Trombosit, marioqqlounge.com, 1200 x 642, png, trombosit fungsi makanan meningkatkan, 20, gambar-trombosit-di-mikroskop, KAMPION
WebJumlah trombosit yang normal di dalam darah yakni 150.000 – 450.000 trombosit per mikroliter (mcL) darah. Dalam situasi dan kondisi tertentu, trombosit bisa. WebGambar di bawah menunjukkan trombosit normal di sebelah kanan. Mereka berbentuk seperti piring, oleh karena itu nama mereka. Ketika trombosit. WebDi bawah ini adalah gambar bakteri yang ada pada kulit manusia. Penampakkan dari telur bakteri. Saraf pada otak kita yang disebut dengan neuron. Sel –. WebTrombosit adalah sel darah yang bertanggung jawab untuk pembekuan darah. Jika dinding pembuluh darah menjadi rusak, trombosit akan bergegas ke tempat. WebDaftar Gambar Trombosit Di Mikroskop Gagasan. Bagian optik merupakan bagian pembuat proyeksi bayangan objek ke mata manusia yang terdiri dari:. WebFoto gratis: tebal, film, mikrograf, malariae, organisme, trombosit, tumpukan, malaria, mikroskop gambar, film, platelet, tumpukan. Web/ Mikroskop gambar / Malaria / dua, vivax mikrograf, trophozoites, menyatu, trombosit, diperbesar, 1125 x. dua, vivax mikrograf, trophozoites, menyatu, trombosit, diperbesar,. WebGambaran Hasil Pemeriksaan Trombosit Darah pada Penderita DBD Sesudah Mengkonsumsi Jambu Biji ( psidium guajava ) di RST Solok Tahun 2018. Journal of. WebAdapun bentuk leukosit , trombosit, limfosit, monosit, neutrofil, Eosinophil dan basophil baik pada ikan betok dan gabus semuanya berbentuk bundar. Hal ini berhubungan dengan.
Viral Trombosit dan Eritrosit selengkapnya
Berikut ZOOM BENTUK TROMBOSIT DARAH DENGAN MIKROSKOP ELEKTRON - DIRGA BIOLOGY CHANNEL selengkapnya
Deskripsi lain dari Gambar Trombosit Di Mikroskop dari pembahasan tadi
Ahli Teknologi Laboratorium Medik dalam bekerja di Laboratorium Medik
Pembahasan Makanan Yang Bisa Meningkatkan Fungsi Trombosit
Berita Trombosit: Fungsi Hingga Kadar Normal Dalam Tubuh Terbaru

Berita Daftar Penyebab Trombosit Tinggi yang Harus Anda Waspadai sedang viral

Foto Gambar Sel Darah Merah Sel Darah Putih Dan Keping Darah : Ciri, Fungsi populer

Mari simak LAPORAN PRAKTIKUM MIKROBIOLOGI: Pewarnaan Bakteri | Envy White Rose

Perlu simak Pemeriksaan Liquor Cerebro Spinalis | Analis Kesehatan sedang viral

Ulasan BELAJAR TERUS BIOLOGI: DARAH Terbaru
Terbaru Gambar Keping Darah Trombosit - Info Terkait Gambar

Lihat sel dan jaringan hewan ~ Prapatan SPS populer

Seri - Seri Leukosit | Analis Kesehatan

No comments:
Post a Comment